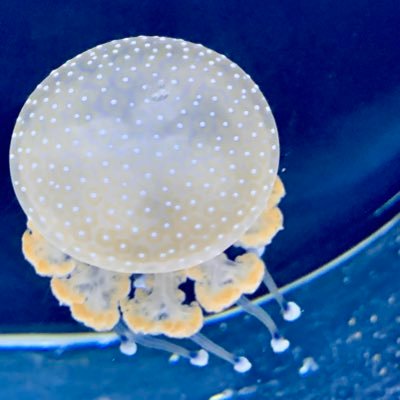
Lclaelf's profile picture. wine music & laughs

#lcdsoundsystem search results
First time as #ConcertPeople at the @HollywoodBowl seeing @welovepulp and @lcdsoundsystem @Concert_People #Disco2000 #lcdsoundsystem



And so you wanted a hit Well this is how we do hits You wanted a hit But that's not what we do #lcdsoundsystem #hollywoodbowl


Tom Blyth wearing #AllSaints Niles Suede Biker Jacket ($570) and #LCDSoundsystem 2022 World Tour T-Shirt ($30)

There are few things more special than your only kid sharing some of your music taste and enjoying your first ( as an adult) festival together.. #lcdsoundsystem #Underworld #forwardfestival

Second gig of the weekend, @lcdsoundsystem at @O2AcademyBrix. Never disappoint and the best live act this side of 00s🕺⚡#LCDSoundsystem #Brixton



#今宵の1枚 #arcadefire #lcdsoundsystem 「Poupée De Cire, Poupée De Son(Arcade Fire) / No Love Lost(LCD Soundsystem)(🇺🇸original 7inch / Merge / MRG313 / Sep 2007)」 個人的には夢の共演が実現した激アツなスプリット7インチ盤を今宵は聴きます🎧…

Now playing LCD Soundsystem album "American Dream", compact disc edition. #lcdsoundsystem #americandream #cd




📢 LCD Soundsystem Tickets 🎤 LCD Soundsystem @ Main Space at Knockdown Center, Maspeth, NY, USA 🗓️ Fri 21 Nov 2025 8:00 PM 🎟️ Get Tickets at prf.hn/l/6l5Qm1x/ #LCDSoundsystem #LCDSoundsystemTickets #LCDSoundsystemMaspeth #LCDSoundsysteminMaspeth

📢 LCD Soundsystem Tickets 🎤 LCD Soundsystem 📍 Main Space at Knockdown Center, Maspeth, NY, USA 🗓️ Fri 21 Nov 2025 8:00 PM 🎟️ Get Tickets at prf.hn/l/6l5Qm1x/ #LCDSoundsystem #LCDSoundsystemTickets #LCDSoundsystemMaspeth #LCDSoundsysteminMaspeth

Hmu if you are interested in buying my 2x LCD Soundsystem today tickets Friday, November 21st at Knockdown Center, Queens, NY. Dm me if you want them please #lcdsoundsystem
📢 LCD Soundsystem Tickets 🎤 LCD Soundsystem 📍 Main Space at Knockdown Center, Maspeth, NY, USA 🗓️ Thu 20 Nov 2025 8:00 PM 🎟️ Get Tickets at prf.hn/l/55DngkZ/ #LCDSoundsystem #LCDSoundsystemTickets #LCDSoundsystemMaspeth #LCDSoundsysteminMaspeth

📢 LCD Soundsystem Tickets 🎤 LCD Soundsystem 📍 Main Space at Knockdown Center, Maspeth, NY, USA 🗓️ Thu 20 Nov 2025 8:00 PM 🎟️ Get Tickets at prf.hn/l/55DngkZ/ #LCDSoundsystem #LCDSoundsystemTickets #LCDSoundsystemMaspeth #LCDSoundsysteminMaspeth

LCD Soundsystem – Never as Tired as When I’m Waking Up now playing on joe doc authorised chill – crags radio ⏰ @lcdsoundsystem #IndieElectronic #LCDSoundsystem #MorningVibes #Groove #NowListening
LCD Soundsystem - All My Friends (Official Video) youtu.be/aygY5OqMuKE?si… @YouTubeより LCDって、同ジャンルのアーティストに比べて詞の量が多いところが違和感あって好きなのかも。 大概繰り返し、2パターンくらいのイメージ。 #lcdsoundsystem ライブ行きたい🐦

youtube.com
YouTube
LCD Soundsystem - All My Friends (Official Video)
Discos que cumplen 20 años: el disco homónimo debut de LCD Soundsystem, lanzado el 24 de enero de 2005 por el sello discográfico Capitol Records. El álbum fue nominado a los Grammys por Best Electronic/Dance Album. #LCDSoundsystem #JamesMurphy #ElectronicMusic #2000s #CDs 💿


Sometimes you see what others don’t #lcdsoundsystem youtu.be/qwoLACv_srQ?si…

youtube.com
YouTube
LCD Soundsystem - Someone Great (Official Video)
BestEverAlbums.com album of the day (#5413) is Sound Of Silver by LCD Soundsystem from 2007. Rankings: 2nd 2007 | 11th 2000s | 107th all-time | Track pick: New York, I Love You But You're Bringing Me Down #lcdsoundsystem #Music #2000s

LCD Soundsystem Tickets LCD Soundsystem Nov 20 • Thu • 8:00PM • 2025 Main Space at Knockdown Center Buy Tickets prf.hn/l/70wMOv1/ #LCDSoundsystem #LCDSoundsystemTickets

LCD Soundsystem Tickets LCD Soundsystem Nov 20 • Thu • 8:00PM • 2025 Main Space at Knockdown Center Buy Tickets prf.hn/l/70wMOv1/ #LCDSoundsystem #LCDSoundsystemTickets

#ICYMI: LIVE REVIEW: @welovepulp & @lcdsoundsystem at @HollywoodBowl music.mxdwn.com/2025/09/27/rev… #pulpband #lcdsoundsystem #hollywoodbowl

.@lcdsoundsystem & @welovepulp Perform Heaven 17's ( @heaven17bef ) "(We Don't Need This) Fascist Groove Thang" music.mxdwn.com/2025/09/27/new… #lcdsoundsystem #pulp #heaven17

First time as #ConcertPeople at the @HollywoodBowl seeing @welovepulp and @lcdsoundsystem @Concert_People #Disco2000 #lcdsoundsystem



And a rainbow came out for @lcdsoundsystem at @MalahideCastleG to celebrate their biggest ever (non-festival) headline gig #LCDSoundsystem #WillPerformForAPassport #HassleAtTheCastle



Tom Blyth wearing #AllSaints Niles Suede Biker Jacket ($570) and #LCDSoundsystem 2022 World Tour T-Shirt ($30)

Quelques images d’hier soir de #lcdsoundsystem , encore et encore un fuck&@€*% show, décidément l’été débute bien 😊




SEATTLE 🗣️🪩 @lcdsoundsystem WEEKEND IS FINALLY HERE! 🪩 4 nights under the disco balls! 😝 #STGPresents #LCDSoundsystem

⚡️ ⫸ turntablelab.com/lcd @lcdsoundsystem #lcdsoundsystem #soundofsilver #thisishappening #indiesleaze #dfa #dfarecords #jamesmurphy

And so you wanted a hit Well this is how we do hits You wanted a hit But that's not what we do #lcdsoundsystem #hollywoodbowl



Now playing LCD Soundsystem album "American Dream", compact disc edition. #lcdsoundsystem #americandream #cd




#ICYMI: LIVE REVIEW: @welovepulp & @lcdsoundsystem at @HollywoodBowl music.mxdwn.com/2025/09/27/rev… #pulpband #lcdsoundsystem #hollywoodbowl

There are few things more special than your only kid sharing some of your music taste and enjoying your first ( as an adult) festival together.. #lcdsoundsystem #Underworld #forwardfestival

Something went wrong.
Something went wrong.
United States Trends
- 1. Travis Head 15K posts
- 2. Caleb Love 2,995 posts
- 3. Mamdani 479K posts
- 4. Marjorie Taylor Greene 74K posts
- 5. Sengun 8,842 posts
- 6. Suns 21.6K posts
- 7. Morgan Geekie N/A
- 8. Norvell 3,581 posts
- 9. Lando 50.4K posts
- 10. UNLV 2,280 posts
- 11. Kerr 5,376 posts
- 12. #SmackDown 48.4K posts
- 13. Collin Gillespie 4,150 posts
- 14. #DBLF2025 14.2K posts
- 15. Blazers 4,115 posts
- 16. Wolves 16.9K posts
- 17. The View 101K posts
- 18. #Ashes2025 30.5K posts
- 19. joshua 103K posts
- 20. Florida State 10.9K posts